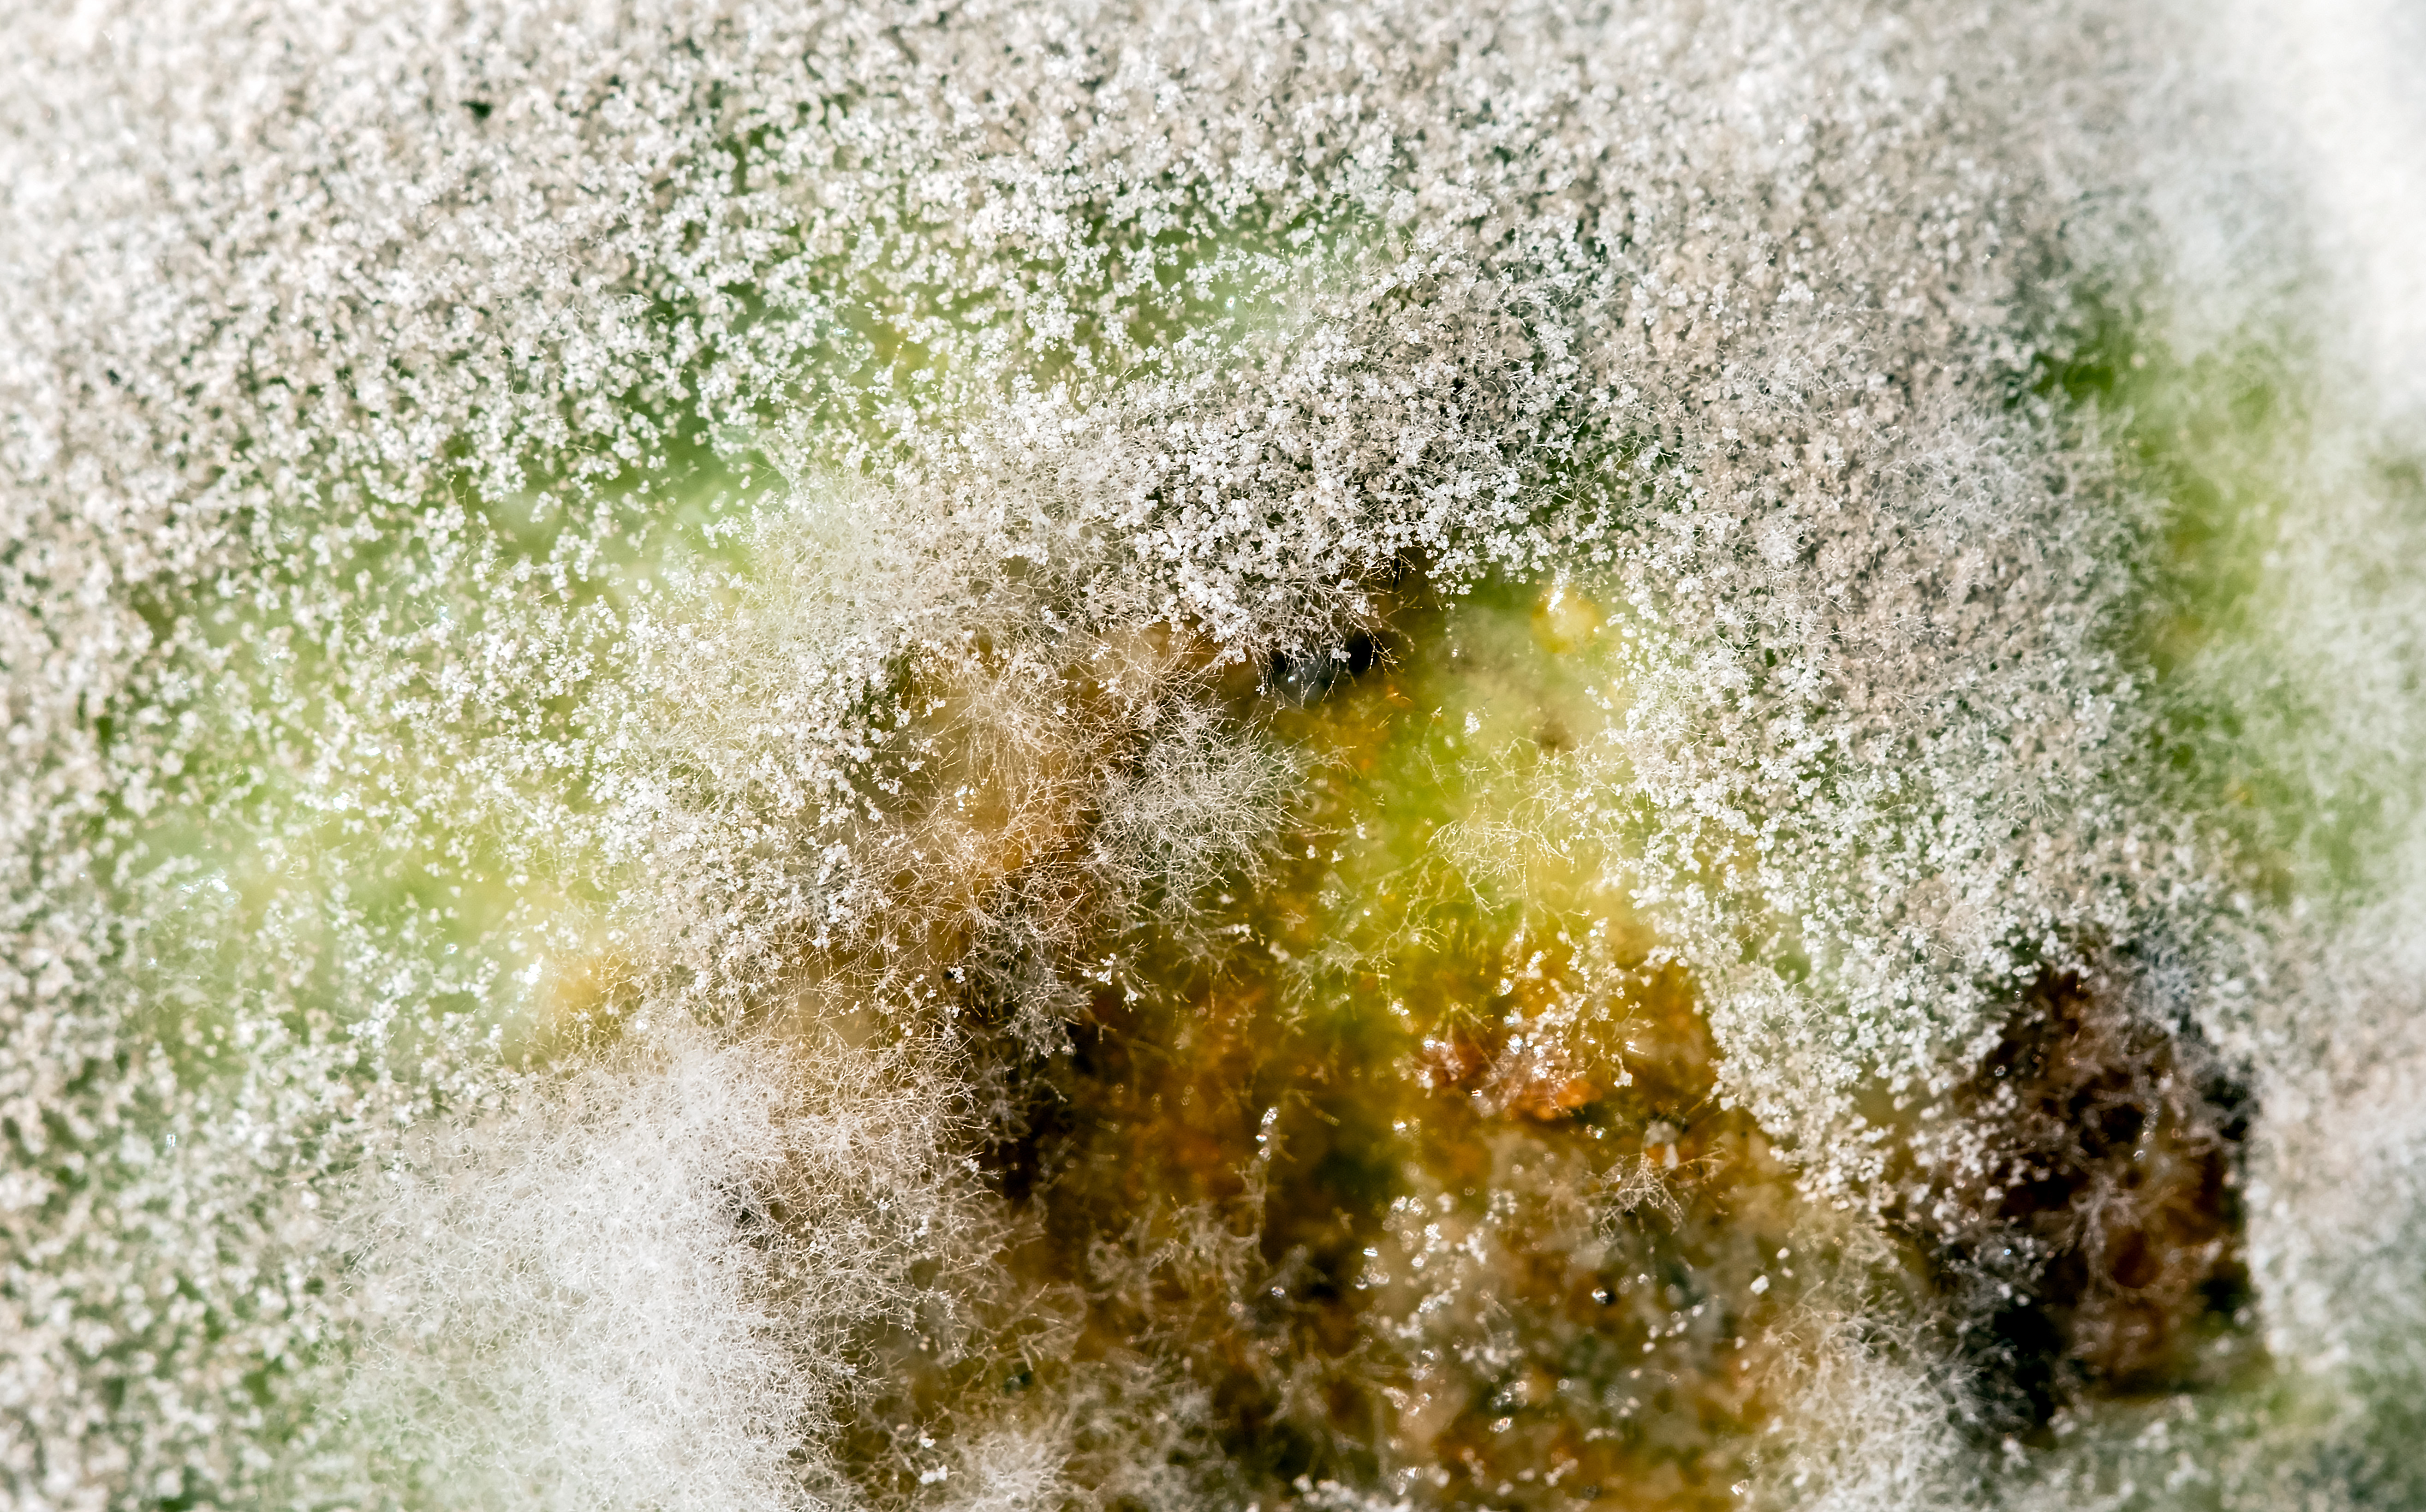

11 Things You Didn't Know About Taking Statins for Cholesterol
In the realm of modern medicine, few drugs have had as profound an impact on public health as statins. These cholesterol-lowering medications have become a cornerstone in the fight against cardiovascular diseases, prescribed to millions worldwide. Yet, despite their widespread use, the world of statins remains shrouded in mystery and misconceptions. This article embarks on a journey to uncover 11 captivating secrets about statins and their role in managing cholesterol. From their biochemical magic to the controversies they stir, each section promises to reveal insights that challenge conventional wisdom and deepen our understanding of these pharmaceutical marvels.
1. The Origins of Statins: From Fungi to Pharmaceuticals
Believe it or not, the journey of statins didn't start in a sterile lab, but with humble mold. In the 1970s, Japanese scientist Akira Endo, studying fungi, discovered compounds that naturally blocked cholesterol production. This pivotal finding, particularly from Aspergillus terreus, led directly to lovastatin, the first statin drug. It was a remarkable path, driven by meticulous research meeting sheer serendipity, demonstrating how potent medicines can arise from unexpected corners of the natural world and ushering in a new age of cardiovascular treatment.
2. The Biochemical Magic: How Statins Work

How do statins perform their cholesterol-lowering feat? It's a feat of precise biochemical intervention. Inside your liver, an enzyme called HMG-CoA reductase acts like a master switch for cholesterol production. Statins expertly target and inhibit this specific enzyme. By flipping this switch 'off', they significantly reduce the liver's cholesterol manufacturing. This forces the liver to pull more LDL ("bad") cholesterol from the bloodstream to compensate, ultimately lowering your circulating LDL levels and reducing cardiovascular risk – a testament to targeted molecular medicine.
